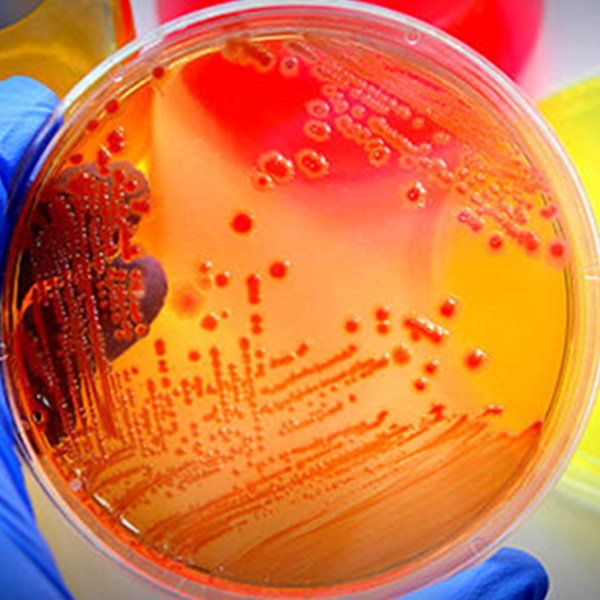

contac@lebialalab.cg
+242 06.938.78.77/ 05.331.53.53
Le BIALA, société à responsabilité limité unipersonnel (SARLU) crée en 2013, elle est constituée de deux unités à savoir: Le laboratoire d'analyses Médical de Louandjiliet de Biala boutique.
En savoir plus
Nous sommes un Laboratoire d'Analyses Médicales expérmenté que vous pouvez faire confiance comme les autres avant vous.

N’hésitez pas. Nous sommes la pour vous.

Dolores sed duo clita justo dolor et stet lorem kasd dolore lorem ipsum. At lorem lorem magna ut et, nonumy labore diam erat. Erat dolor rebum sit ipsum.

Dolores sed duo clita justo dolor et stet lorem kasd dolore lorem ipsum. At lorem lorem magna ut et, nonumy labore diam erat. Erat dolor rebum sit ipsum.
Rond-Point Loandjili/ Pointe- Noire
contact@lebialalab.cg
+242 06.938.78.77/ 05.331.53.53
© Lebiala